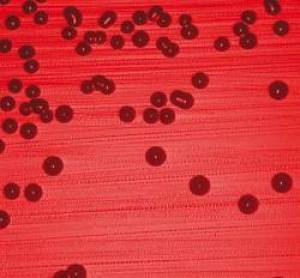
SEPSA – co kosmetolog wiedzieć powinien
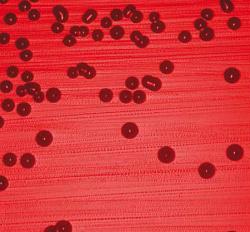
sepsblood

Wypadanie włosów to coraz powszechniejszy problem – głównie, choć nie wyłącznie, dla mężczyzn. Przyczyny tego zjawiska są mocno zróżnicowane, szeroki też jest wachlarz poten- cjalnych rozwiązań profilaktycznych. Gabinety kosmetyczne oraz producenci oferują szereg za- biegów oraz środków zapobiegających łysieniu: mezoterapia, laseroterapia, naświetlania, am- pułki, suplementy itd. Żaden z nich jednak nie wydaje się być w pełni satysfakcjonujący. Naj- większą nadzieję dają przeszczepy włosów. Choć nie są jeszcze doskonałe, to postęp, jaki obser- wujemy w tej dziedzinie, napawa optymizmem.
Wypadanie włosów to coraz powszechniejszy problem – głównie, choć nie wyłącznie, dla mężczyzn. Przyczyny tego zjawiska są mocno zróżnicowane, szeroki też jest wachlarz poten- cjalnych rozwiązań profilaktycznych. Gabinety kosmetyczne oraz producenci oferują szereg za- biegów oraz środków zapobiegających łysieniu: mezoterapia, laseroterapia, naświetlania, am- pułki, suplementy itd. Żaden z nich jednak nie wydaje się być w pełni satysfakcjonujący. Naj- większą nadzieję dają przeszczepy włosów. Choć nie są jeszcze doskonałe, to postęp, jaki obser- wujemy w tej dziedzinie, napawa optymizmem.
Przeszczepy włosów - przegląd metod
Za prekursorów przeszczepów włosów można uznać japońskich dermatologów (dr Okuda oraz dr Tamura), którzy w latach 40. ubiegłego wieku jako pierwsi dokonywali takich operacji. Ze względu jednak na trwającą wojnę i hermetyczność lokalnego środowiska medycznego, ich osiągnięcia nie były znane poza Japonią. Niejako „powtórnym odkrywcą” transplantacji włosów został w roku 1952 dr Norman Oren- treich z Nowego Jorku. Techniki wypracowane przez Japończyków i dr Orentreicha były róż- ne, ich wspólną jednak niedoskonałością było wszczepianie całych pęczków włosów, czego wynikiem był bardzo nienaturalny wygląd.
 Metoda strip
Metoda strip
Dalsze prace doprowadziły do wypracowania standardów dla metody określanej powszechnie jako STRIP, co po angielsku oznacza „pasek”. Taki właśnie kształt (około 15 cm x 1-2 cm) ma wycięcie – zazwyczaj z okolicy potylicznej. Z tego paska zespół asystujący, z pomocą mikroskopów i skalpeli, wycina pojedyncze grafty i przygoto- wuje je do implantacji. Skóra głowy jest naciągana, a krawędzie nacięcia zszywane ze sobą.
Kolejnym etapem zabiegu jest dokonanie nacięć skóry w obszarze, gdzie dokonana będzie implantacja przygotowanego materiału. Ostatnim etapem zabiegu jest wprowadzenie przygotowanych graftów w nacięcia na skórze.
Wady i zalety
Zasadniczą wadą jest dość znaczna traumatycz- ność zabiegu dla pacjenta oraz pozostająca po nim blizna, która nie zawsze daje się skutecznie zamaskować przez fryzurę. Pojawiają się także problemy z gojeniem się rany, a także z uszkodzeniami nerwów w obszarze pobierania materiału. Skuteczne stosowanie metody STRIP związane jest także z koniecznością posiadania wysoce specjalistycznego sprzętu (mikroskopy) i licznego zespołu asystującego, o najwyższych kompetencjach i znacznym doświadczeniu. Zaletą jest możliwość wykonania przeszczepu relatywnie dużej liczby włosów w jednym zabiegu (nawet do 3 tysię- cy punktów) oraz – w porównaniu do kolejnej metody, FUE – mniejsza czasochłonność zabiegu.
 Metoda fue
Metoda fue
Na przełomie XX i XXI wieku pojawiła się i zyskała pewne uznanie metoda, która w swoim założeniu miała usunąć główną wadę metody STRIP, czyli wycięcie paska skóry i nieuchronnie związane z tym pojawienie się blizny. W metodzie FUE (Follicular Unit Extraction) pobiera się pojedyncze mieszki włosowe. Chirurg używa do tego specjalnego narzędzia zwanego micro-punch.
W kolejnej fazie wszczepia się pobrany materiał w nacięcia skóry wykonane skalpelem (lub igłą) w obszarze docelowym.
 Robot artas
Robot artas
Zdecydowanym krokiem naprzód w rozwoju technik przeszczepu włosów jest wykorzystanie do zabiegu maszyn i robotów. Robot ARTAS to wynalazek amerykański, promowany przez dra Samuela Lama oraz firmę Restorations Robotics. Jednak robot w zasadzie tylko wspomaga pracę chirurga – służy do dokonywania nakłuć skóry w obszarze donorowym.
Pozostałe fazy zabiegu – pobranie materiału za pomocą szczypiec oraz wszystkie etapy wszczepiania graftów – wykonywane są nadal ręcznie. Robot posiada także szereg innych ograniczeń, na przykład co do koloru i rodzaju włosów.
 System safer
System safer
Zarówno na rynku amerykańskim, jak i europejskim popularność zdobywa natomiast system francuskiej firmy Medicamat - SAFER (w USA promowany pod marką NeoGraft). Technologia SAFER usuwa podstawową słabość metody FUE: ryzyko uszkodzenia graftów. W ramach zabiegu wykonywa- nego w technologii SAFER, ostrze wnika w głąb skóry jedynie na głębokość około 1 mm, a cała struktura włosa wyciągana jest przez podciśnienie. Tym samym niwelowane jest (prak- tycznie do zera) ryzyko mechanicznych uszkodzeń cebulki włosa. W drugiej fazie zabiegu, podczas wszczepiania graftów, także wykorzystywane są pneumatyczne głowice, któ- re „wstrzeliwują” je w wykonane skalpelem nacięcia w skórze.
Wady i zalety
Główną zaletą metody FUE jest brak blizn – okrągłe nacięcia po pobraniu graftów są na tyle małe (zazwyczaj poniżej 1 mm średnicy), że gojenie ranki postępuje bardzo szybko i zostawia minimalny ślad, który doskonale daje się ukryć nawet pod bardzo krótkimi włosami. Wadą metody FUE jest jej bardzo duża pracochłonność i – zdaniem niektórych – ograniczenie liczby przeszczepianych graftów do kilkuset punktów. Najpoważniejsza jednak wada metody FUE związana jest z ryzykiem uszkodzenia delikatnych struktur cebulki włosa podczas pobierania. Micropunch musi wejść w głąb skóry na około 3 mm, chirurg musi wprowadzać narzędzie dokładnie osiowo wzdłuż włosa. To bardzo trudne – tylko niezwykle sprawni operatorzy osią- gają skuteczność ponad 90% nieuszkodzonych graftów. Podczas zabiegu wykonanego przez mniej doświadczonego operatora liczba uszkodzonych graftów może zbliżać się nawet do 25-30%.
Na rynku funkcjonuje kilka rozwiązań, które mają ułatwiać pracę ope- ratorów wykonujących zabieg metodą FUE. Są to w większości ręczne przyrządy, przyspieszają- ce pobieranie graftów (np. przyrząd dr Lorenzo) czy ich implantację (np. tak zwany Choi Implanter, dr Choi z Korei). Jednak o ile bardzo prawdopodobne jest, że korzystanie z tych specjalistycznych narzę- dzi może skrócić czas operacji metodą FUE, o tyle podsta- wowa wada metody – wysokie ryzyko uszkodzeń struktur pobieranych włosów – nadal pozostanie nieusunięta.
Sprzęt prezentowany jest na kongresach branżowych (Monte Carlo, Paryż), gdzie omawiane są także nieco bar- dziej „egzotyczne” zastosowania maszyny – korekta linii brwi czy uzupełnianie rzęs.
Prawdopodobnie większość zabiegów przeszczepu włosów wykonywana jest dziś w technologii STRIP. Wydaje się, że za- lety techniki FUE będą coraz bardziej przeważać – w szczególności wobec postępów w automatyzacji zabiegu. Jednak można być pewnym, że prawdziwa rewolucja w tym obszarze nadejdzie za kilkanaście lat, gdy opanowane zostaną metody „klonowania” włosów z wykorzystaniem tzw. komórek macierzystych. Dopiero ta technologia usunie fundamentalny problem – ograniczone zasoby graftów do przeszczepu.
Źródło: Kosmetologia Estetyczna

























 Co zrobić kiedy tradycyjny tatuaż lub makijaż permanentny bardziej szpeci niż ozdabia? Odpowiedź jest prosta – udać się do gabinetu medycyny estetycznej, gdzie pod okiem doświadczonego lekarza zostanie on usunięty. Jednak zanim tatuaż na dobre zniknie z Twojego ciała, czeka Cię jeszcze długa droga. Musisz wiedzieć, że proces usuwania zależy od tego, jakiego rodzaju i koloru jest twój emblemat. To właśnie według tego zostanie dobrana odpowiednia metoda jego usuwania i określony czas terapii.
Co zrobić kiedy tradycyjny tatuaż lub makijaż permanentny bardziej szpeci niż ozdabia? Odpowiedź jest prosta – udać się do gabinetu medycyny estetycznej, gdzie pod okiem doświadczonego lekarza zostanie on usunięty. Jednak zanim tatuaż na dobre zniknie z Twojego ciała, czeka Cię jeszcze długa droga. Musisz wiedzieć, że proces usuwania zależy od tego, jakiego rodzaju i koloru jest twój emblemat. To właśnie według tego zostanie dobrana odpowiednia metoda jego usuwania i określony czas terapii.
 Jeszcze nie tak dawno, żeby zamieszkać razem, trzeba było się pobrać, bo tak nakazywały zasady moralne. Dziś małżeństwo przestało być postrzegane jako norma społeczna. Coraz więcej par mieszka z sobą bez ślubu i nie potrzebują formalizowania związku. Nawet w krajach mocno katolickich współżycie seksualne przed ślubem już nikogo nie szokuje. W efekcie rośnie liczba ludzi żyjących w konkubinacie, szczególnie tych młodych. Kiedyś główna przyczyną zniechęcającą do legalizacji związku był brak zabezpieczenia materialnego.
Jeszcze nie tak dawno, żeby zamieszkać razem, trzeba było się pobrać, bo tak nakazywały zasady moralne. Dziś małżeństwo przestało być postrzegane jako norma społeczna. Coraz więcej par mieszka z sobą bez ślubu i nie potrzebują formalizowania związku. Nawet w krajach mocno katolickich współżycie seksualne przed ślubem już nikogo nie szokuje. W efekcie rośnie liczba ludzi żyjących w konkubinacie, szczególnie tych młodych. Kiedyś główna przyczyną zniechęcającą do legalizacji związku był brak zabezpieczenia materialnego.
 Komórki macierzyste mogą przekształcać się w każdą komórkę, potem tkankę. Zależy to od genu, który do nich trafi i je ukierunkuje. Każda komórka zawierająca materiał genetyczny ma swoją specjalizację. W zależności które geny się włączają, a które wyciszają, powstają wyspecjalizowane komórki, z których „buduje się” np. serce.
Komórki macierzyste mogą przekształcać się w każdą komórkę, potem tkankę. Zależy to od genu, który do nich trafi i je ukierunkuje. Każda komórka zawierająca materiał genetyczny ma swoją specjalizację. W zależności które geny się włączają, a które wyciszają, powstają wyspecjalizowane komórki, z których „buduje się” np. serce.
 Wybierając serum należy pamiętać, że jest to kosmetyk o wyspecjalizowanym działaniu. Dlatego też zanim sięgniemy po ten rodzaj pielęgnacji warto jasno sprecyzować potrzeby swojej skóry.
Wybierając serum należy pamiętać, że jest to kosmetyk o wyspecjalizowanym działaniu. Dlatego też zanim sięgniemy po ten rodzaj pielęgnacji warto jasno sprecyzować potrzeby swojej skóry.
 Wypadanie włosów to coraz powszechniejszy problem – głównie, choć nie wyłącznie, dla mężczyzn. Przyczyny tego zjawiska są mocno zróżnicowane, szeroki też jest wachlarz poten- cjalnych rozwiązań profilaktycznych. Gabinety kosmetyczne oraz producenci oferują szereg za- biegów oraz środków zapobiegających łysieniu: mezoterapia, laseroterapia, naświetlania, am- pułki, suplementy itd. Żaden z nich jednak nie wydaje się być w pełni satysfakcjonujący. Naj- większą nadzieję dają przeszczepy włosów. Choć nie są jeszcze doskonałe, to postęp, jaki obser- wujemy w tej dziedzinie, napawa optymizmem.
Wypadanie włosów to coraz powszechniejszy problem – głównie, choć nie wyłącznie, dla mężczyzn. Przyczyny tego zjawiska są mocno zróżnicowane, szeroki też jest wachlarz poten- cjalnych rozwiązań profilaktycznych. Gabinety kosmetyczne oraz producenci oferują szereg za- biegów oraz środków zapobiegających łysieniu: mezoterapia, laseroterapia, naświetlania, am- pułki, suplementy itd. Żaden z nich jednak nie wydaje się być w pełni satysfakcjonujący. Naj- większą nadzieję dają przeszczepy włosów. Choć nie są jeszcze doskonałe, to postęp, jaki obser- wujemy w tej dziedzinie, napawa optymizmem. Metoda strip
Metoda strip Metoda fue
Metoda fue Robot artas
Robot artas System safer
System safer


 Podrażniona skóra jest jednym z najczęstszych problemów po zabiegach w gabinecie kosmetycznym. Po mimo tego, ze kosmetyczka zadba o uspokojenie skóry, warto taką pielęgnację kontynuować w domu.
Podrażniona skóra jest jednym z najczęstszych problemów po zabiegach w gabinecie kosmetycznym. Po mimo tego, ze kosmetyczka zadba o uspokojenie skóry, warto taką pielęgnację kontynuować w domu.
 Liposukcja to od wielu już lat jeden z najpopularniejszych zabiegów chirurgicznych w me- dycynie estetycznej. Co roku korzysta z niego ponad pół miliona Amerykanek. Fraza ta jest też bardzo często wykorzystywana w branżowej komunikacji marketingowej – tak w obszarze medycyny jak i kosmetyki (gdzie zazwyczaj dodawane jest wtedy słowo „niein- wazyjna”). W niniejszym materiale postaram się dokonać ogólnego przeglądu dostępnych metod liposukcji chirurgicznej oraz nieinwa- zyjnej, a także ocenić ich skuteczność.
Liposukcja to od wielu już lat jeden z najpopularniejszych zabiegów chirurgicznych w me- dycynie estetycznej. Co roku korzysta z niego ponad pół miliona Amerykanek. Fraza ta jest też bardzo często wykorzystywana w branżowej komunikacji marketingowej – tak w obszarze medycyny jak i kosmetyki (gdzie zazwyczaj dodawane jest wtedy słowo „niein- wazyjna”). W niniejszym materiale postaram się dokonać ogólnego przeglądu dostępnych metod liposukcji chirurgicznej oraz nieinwa- zyjnej, a także ocenić ich skuteczność.
Układ immunologiczny człowieka ma za zadanie bronić organizm przed patogenami. Zdarza się jednak, że drobnoustroje po- konują te bariery i wnikają do organizmu. Zarówno cechy bakterii, jak i sprawność układu immunologicznego gospodarza decy- dują o intensywności i czasie trwania inwazji bakteryjnej. Najbardziej obawiamy się sepsy, o której bywa głośno w mediach. Czym tak naprawdę jest sepsa?
Układ immunologiczny człowieka ma za zadanie bronić organizm przed patogenami. Zdarza się jednak, że drobnoustroje po- konują te bariery i wnikają do organizmu. Zarówno cechy bakterii, jak i sprawność układu immunologicznego gospodarza decy- dują o intensywności i czasie trwania inwazji bakteryjnej. Najbardziej obawiamy się sepsy, o której bywa głośno w mediach. Czym tak naprawdę jest sepsa?